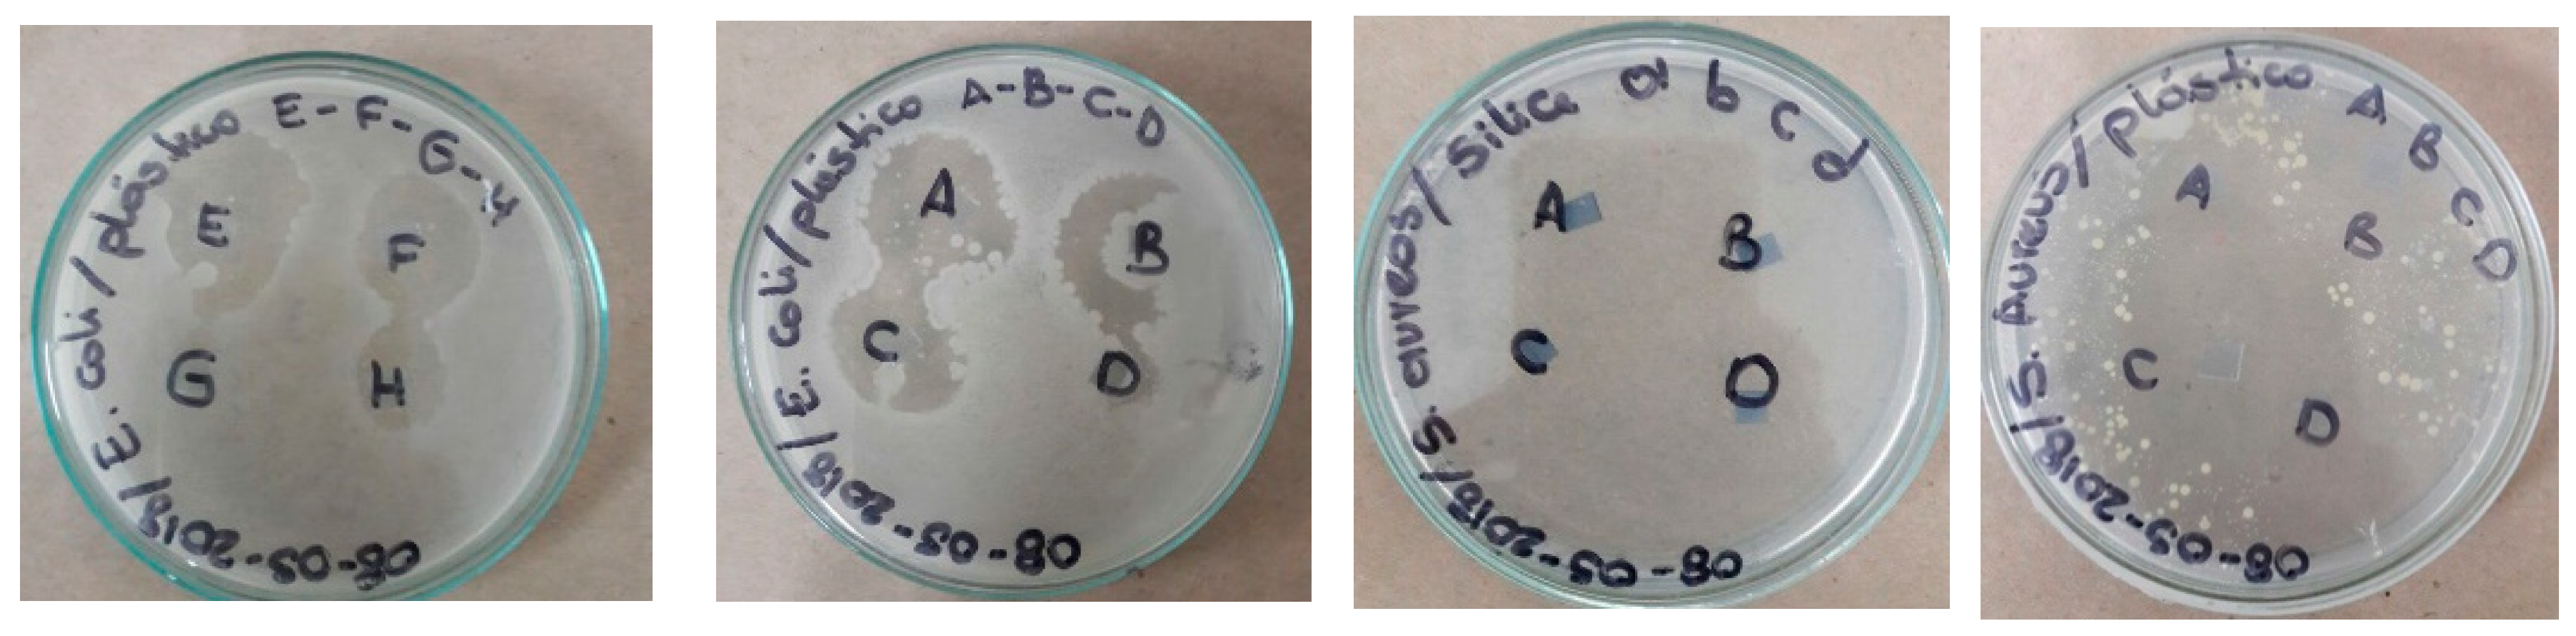
Colloids 03 00025 g007 Colloids 03 00025 g007

Colloidal Metal Oxide Nanoparticles Prepared by Laser Ablation Technique and Their Antibacterial Test
Abstract
1. Introduction
2. Materials and Methods
2.1. Synthesis of Metal Oxide Nanoparticles
2.2. Characterizations of Metal Oxide Nanoparticles
2.3. Microbiological Experiment
3. Results and Discussion
3.1. UV-Vis Analysis
3.2. Band Gap Estimation
3.3. FTIR Analysis
3.4. Scanning Electron Microscopy
4. Application as Antibacterial Surfaces
5. Conclusions
Author Contributions
Funding
Acknowledgments
Conflicts of Interest
References
- Afshar, E.; Mohammadi-Manesh, H.; Khavidaki, H.D. Removal of Hg (I) and Hg (II) Ions from Aqueous Solutions, Using TiO2 Nanoparticles. Pollution 2017, 3, 505–516. [Google Scholar] [CrossRef]
- Nica, I.C.; Stan, M.S.; Popa, M.; Chifiriuc, M.C.; Lazar, V.; Pircalabioru, G.G.; Dumitrescu, I.; Ignat, M.; Feder, M.; Tanase, L.C.; et al. Interaction of New-Developed TiO2-Based Photocatalytic Nanoparticles with Pathogenic Microorganisms and Human Dermal and Pulmonary Fibroblasts. Int. J. Mol. Sci. 2017, 18, 249. [Google Scholar] [CrossRef] [PubMed]
- Tan, Y.N.; Ayob, M.K.; Yaacob, W.W.A. Purification and characterisation of antibacterial peptide-containing compound derived from palm kernel cake. Food Chem. 2013, 136, 279–284. [Google Scholar] [CrossRef] [PubMed]
- Dave, P.N.; Chopda, L.V. Application of Iron Oxide Nanomaterials for the Removal of Heavy Metals. J. Nanotechnol. 2014, 2014, 396589. [Google Scholar] [CrossRef]
- Sharma, Y.C.; Srivastava, V.; Singh, V.K.; Kaul, S.N.; Weng, C.H. Nano-adsorbents for the removal of metallic pollutants from water and wastewater. Environ. Technol. 2009, 30, 583–609. [Google Scholar] [CrossRef] [PubMed]
- Man, Z.; Ziyada, A.K.; Bustam, M.A.; Mutalib, A.; Wilfred, C.D. Thermophysical Properties of Dual Functionalized Imidazolium-Based Ionic Liquids. J. Environ. Chem. Eng. 2014, 2, 642–651. [Google Scholar] [CrossRef]
- Sung, L.P.; Scierka, S.; Baghai-Anaraki, I.; Ho, D.L. Characterization of Metal-Oxide Nanoparticles: Synthesis and Dispersion in Polymeric Coatings. Mater. Res. Soc. 2003, 740. [Google Scholar] [CrossRef]
- Yan, J.; Liu, P.; Ma, C.; Lin, Z.; Yang, G. Plasmonic near-touching titanium oxide nanoparticles to realize solar energy harvesting and effective local heating. Nanoscale 2016, 8, 8826–8838. [Google Scholar] [CrossRef]
- Jensen, T.R.; Malinsky, M.D.; Christy, L. Tunable Localized Surface Plasmon Resonance Spectra of Silver Nanoparticles. Haynes. J. Phys. Chem. B 2000, 104, 10549–10556. [Google Scholar] [CrossRef]
- Willets, K.A.; Van Duyne, R.P. Localized surface plasmon resonance spectroscopy and sensing. Annu. Rev. Phys. Chem. 2007, 58, 267–297. [Google Scholar] [CrossRef]
- Soelberg, S.D.; Stevens, R.C.; Limaye, A.P.; Furlong, C.E. Surface Plasmon Resonance Detection Using Antibody-Linked Magnetic Nanoparticles for Analyte Capture, Purification, Concentration, and Signal Amplification. Anal. Chem. 2010, 82, 6782–6789. [Google Scholar] [CrossRef]
- Murph, S.E.; Larsen, G.K.; Lascola, R.J. Multifunctional Hybrid Fe2O3-Au Nanoparticles for Efficient Plasmonic Heating. J. Vis. Exp. 2016, 108. [Google Scholar] [CrossRef]
- Jung, M.; Ji, M.G.; Kim, T.R.; Shim, C.H.; Lee, S.; Woo, D.; Choi, Y.W. Localized surface plasmon resonance in two-dimensional silver nanodot array fabricated using nanoporous alumina mask for chemical sensor platform. Opt. Eng. 2016, 55. [Google Scholar] [CrossRef]
- Soltani, N.; Saion, E.; Hussein, M.Z.; Erfani, M.; Abedini, A.; Bahmanrokh, G.; Navasery, M.; Vaziri, P. Visible light-induced degradation of methylene blue in the presence of photocatalytic ZnS and CdS nanoparticles. Int. J. Mol. Sci. 2012, 13, 12242–12258. [Google Scholar] [CrossRef] [PubMed]
- Janczarek, M.; Kowalska, E. On the Origin of Enhanced Photocatalytic Activity of Copper-Modified Titania in the Oxidative Reaction Systems. Catalysts 2017, 7, 317. [Google Scholar] [CrossRef]
- Yang, Y.T.; Zhu, J.F.; Liao, G.; Xu, H.J.; Yu, B. The Development of Biologically Important Spirooxindoles as New Antimicrobial Agents. Curr. Med. Chem. 2018, 25, 2233–2244. [Google Scholar] [CrossRef]
- Jha, M.; Shimpi, N.G. Green synthesis of zero valent colloidal nanosilver targeting A549 lung cancer cell: In vitro cytotoxicity. J. Genet. Eng. Biotechnol. 2018, 16, 115–124. [Google Scholar] [CrossRef]
- Kelly, K.L.; Coronado, E.; Zhao, L.L.; Schatz, G.C. The optical properties of metal nanoparticles: The influence of size, shape, and dielectric environment. J. Phys. Chem. B 2003, 107, 668–677. [Google Scholar] [CrossRef]
- Hergert, W. Mie Theory, Springer Series in Optical Sciences. Mie Theory 2012, 169, 53. [Google Scholar] [CrossRef]
- Zhang, X.; Chen, Y.L.; Liu, R.S.; Tsai, D.P. Plasmonic photocatalysis. Rep. Prog. Phys. 2013, 76. [Google Scholar] [CrossRef]
- Yamashita, H.; LiY, H. Nanostructured Photocatalysts: Advanced Functional Materials. Appl. Catal. B 2011, 105, 211. [Google Scholar]
- Li, S.; Wang, W.; Liang, F.; Zhang, W.X. Heavy metal removal using nanoscale zero-valent iron (nZVI): Theory and application. J. Hazard. Mater. 2017, 322, 163–171. [Google Scholar] [CrossRef] [PubMed]
- Mansoureh, G.; Parisa, V. Synthesis of metal nanoparticles using laser ablation technique. Emerg. Appl. Nanopart. Archit. Nanostruct. 2018, 575–596. [Google Scholar] [CrossRef]
- Ganjali, M.; Vahdatkhah, P.; Marashid, S.M.B. Synthesis of Ni Nanoparticles by Pulsed Laser Ablation Method in Liquid Phase. Procedia Mater. Sci. 2015, 11, 359–363. [Google Scholar] [CrossRef]
- Hamad, A.; Li, L.; Liu, Z. Comparison of characteristics of selected metallic and metal oxide nanoparticles produced by picosecond laser ablation at 532 and 1064 nm wavelengths. Appl. Phys. A 2016, 122, 904. [Google Scholar] [CrossRef]
- Bozon-Verduras, F.; Breyner, R.; Voronov, V.V. Production of nanoparticles by laser-induced ablation of metals in liquids. Quantum Electron. 2003, 33, 714–720. [Google Scholar] [CrossRef]
- Khan, S.Z.; Yuan, Y.; Abdolvand, A.; Schmidt, M.; Couse, P.; Li, L. Generation and characterization of NiO nanoparticlesby continuous wave fiber laser ablation in liquid. J. Nanopart. Res. 2009, 11, 1421. [Google Scholar] [CrossRef]
- Shukla, A.; Singh, S.C.; Pandey, B.K.; Uttam, K.N.; Shah, J.; Kotnala, R.K.; Gopal, R. Liquid-assisted pulsed laser ablation synthesized titanium ferrite nanoparticles: Structural, optical and magnetic properties. Adv. Mater. Lett. 2015, 6, 1066–1072. [Google Scholar] [CrossRef]
- Kawabata, T.; Fujisaki, N.; Shishido, T.; Nomura, K.; Sano, T.; Takehira, K. Improved Fe/Mg-Al hydrotalcite catalyst for Baeyer–Villiger oxidation of ketones with molecular oxygen and benzaldehyde. J. Mol. Catal. A Chem. 2006, 253, 279–289. [Google Scholar] [CrossRef]
- Ohishi, Y.; Kawabata, T.; Shishido, T.; Takaki, K.; Zhang, Q.; Wang, Y.; Nomura, K.; Takehira, K. Mg–Fe–Al mixed oxides with mesoporous properties prepare from hydrotalcite as precursors: Catalytic behavior in ethylbenzene dehydrogenation. Appl. Catal. A Gen. 2005, 288, 220–223. [Google Scholar] [CrossRef]
- Agúa, U.A.; Oliva, M.I.; Marchetti, S.G.; Heredia, A.C.; Casuscelli, S.G.; Crivello, M.E. Synthesis and characterization of a mixture of CoFe2O4 and MgFe2O4 from layered double hydroxides: Band gap energy and magnetic responses. J. Magn. Magn. Mater. 2013, 234, 38–46. [Google Scholar] [CrossRef]
- Elıas, V.R.; Vaschetto, E.G.; Sapag, K.; Crivello, M.E.; Casuscelli, S.G.; Eime, G.A. Synthesis and Photocatalytic Activity of Titania-Loaded Transition Metal-Modified MCM-41 Molecular Sieves. Top. Catal. 2011, 54, 277–286. [Google Scholar] [CrossRef]
- Ryu, J.H.; Yoon, J.W.; Lim, C.S.; Oh, W.C.; Shim, K.B. Microwave-assisted synthesis of CaMoO4 nano-powders by a citrate complex method and its photoluminescence property. J. Lumin. 2007, 124, 67–70. [Google Scholar] [CrossRef]
- Shukla, A.; Bhardwaj, A.K.; Pandey, B.K.; Singh, S.C.; Uttam, K.N.; Shah, J.; Kotnala, R.K.; Gopal, R. Laser synthesized magnetically recyclable titanium ferrite nanoparticles for photodegradation of dyes. J. Mater. Sci. Mater. Electron. 2017, 28, 15380–15386. [Google Scholar] [CrossRef]
- Duque, J.S.; Blandón, J.S.; Riascos, H. Localized Plasmon resonance in metal nanoparticles using Mie theory. J. Phys. Conf. Ser. 2017, 850. [Google Scholar] [CrossRef]
- Gupta, S.M.; Manoj, T. A review of TiO2 nanoparticles. Chin. Sci. Bull. 2011, 56, 1639–1657. [Google Scholar] [CrossRef]
- Akimoto, S. Takashi Katsura and Minoru Yoshida. J. Geomagn. Geoelectr. 1957, 9, 165–178. [Google Scholar] [CrossRef]
- Tauc, J.; Grigorovici, R.; Vancu, A. Optical Properties and Electronic Structure of Amorphous Germanium. Phys. Status Solidi 1966, 15, 627. [Google Scholar] [CrossRef]
- Ghobadi, N. Band gap determination using absorption spectrum fitting procedure. Int. Nano Lett. 2013, 3. [Google Scholar] [CrossRef]
- Kirchberg, K.; Becker, A.; Bloesser, A.; Weller, T.; Timm, J.; Suchomski, C.; Marschall, R. Stabilization of Monodisperse, Phase-Pure MgFe2O4 Nanoparticles in Aqueous and Nonaqueous Media and Their Photocatalytic Behavior. J. Phys. Chem. C 2017, 121, 27126–27138. [Google Scholar] [CrossRef]
- Sun, S.; Yang, X.; Zhang, Y.; Zhang, F.; Ding, J.; Bao, J.; Gao, C. Enhanced photocatalytic activity of sponge-like ZnFe2O4 synthesized by solution combustion method. Prog. Nat. Sci. 2012, 22, 639–643. [Google Scholar] [CrossRef]
- Theivasanthi, T.; Alagar, M. Lead Nanopowder as Advanced Semi-Conductor, An Insight. Res. Appl. Mater. 2013, 1, 36–43. [Google Scholar] [CrossRef]
- Baset, S.; Akbar, H. Size measurement of metal and semiconductor nanoparticles via uv-vis absorption spectra. Dig. J. Nanomater. Biostruct. 2011, 6, 709–716. [Google Scholar]
- Horiuchi, Y.; Toyao, T.; Miyahara, K.; Zakar, L.; Van, D.D.; Kamata, Y.; Kim, T.H.; Lee, S.W.; Matsuok, M. Visible-light-driven photocatalytic water oxidation catalysed by iron-based metal organic frameworks. Carbohydr. Polym. 2016, 153, 60–65. [Google Scholar] [CrossRef] [PubMed]
- Ghandoor, H.E.; Zidan, H.M.; Khalil, M.M.H.; Ismai, M.I.M. Synthesis and Some Physical Properties of Magnetite (Fe3O4) Nanoparticles. Int. J. Electrochem. Sci. 2012, 7. [Google Scholar]
- Taffa, D.H.; Dillert, R.; Ulpe, A.C.; Bauerfeind, K.C.L.; Bredow, T.; Bahnemann, D.W.; Wark, M. Photoelectrochemical and theoretical investigations of spinel type ferrites (MxFe3−xO4) for water splitting: A mini-review. J. Photonics Energy 2016, 7. [Google Scholar] [CrossRef]
- Dulub, O.; Diebold, U.; Kresse, G. Novel Stabilization Mechanism on Polar Surfaces: ZnO (0001)-Zn. Phys. Rev. Lett. 2003, 90, 016102. [Google Scholar] [CrossRef]
- Ferreira, V.C.; Goddard, A.J.; Monteiro, O.C. In situ synthesis and modification of cotton fibers with bismuthoxychloride and titanium dioxide nanoparticles for photocatalytic applications. J. Photochem. Photobiol. A Chem. 2018, 357, 201–212. [Google Scholar] [CrossRef]

| Metallic Target | 1064 nm Peak Positions | 532 nm Peak Positions | ||
|---|---|---|---|---|
| As− Growth | 1 Month | As− Growth | 1 Month | |
| TiFe2O4 | 300 nm | 325 nm | 210 nm | 342 nm |
| 970 nm | 978 nm | |||
| ZnFe2O4 | 271 nm | 343 nm | 200 nm | 346 nm |
| 975 nm | 980 nm | |||
| Target | Egap (eV) at 1064 nm | Egap (eV) at 1064 nm (1 Month) | Egap (eV) at 532 nm | Egap (eV) at 532 nm (1 Month) |
|---|---|---|---|---|
| TiFe2O4 | 2.17 | 2.20 | 2.20 | 2.25 |
| ZnFe2O4 | 2.27 | 2.27 | 2.25 | 2.20 |
| NPs | Illuminated at 330 nm (h) | Without Light (h) | ||||||
|---|---|---|---|---|---|---|---|---|
| S. aureus | E. coli | S. aureus | E. coli | |||||
| Incubation time at 37 °C | 24 | 48 | 24 | 48 | 24 | 48 | 24 | 48 |
| TiFe2O4, 1064 nm | 23 mm ± 0.1 S | 24 mm ± 0.1 S | 23 mm ± 0.1 S | 24 mm ± 0.1 S | R | R | R | R |
| TiFe2O4, 532 nm | 30 mm ± 0.3 S | 30 mm ± 0.1 S | 28 mm ± 0.3 S | 29 mm ± 0.3 S | R | R | R | R |
| ZnFe2O4, 1064 nm | 17 mm ± 0.1 I | 18 mm ± 0.2 I | 9.7 mm ± 0.2 R | 10 mm ± 0.3 R | R | R | R | R |
| ZnFe2O4, 532 nm | 19 mm ± 0.3 I | 19 mm ± 0.1 I | 20 mm ± 0.1 S | 21 mm ± 0.2 S | R | R | R | R |
| Polyethylene | R | R | R | R | R | R | R | R |
| Positive control (ampicillin) | 23 mm | 23 mm | 23 mm | 23 mm | 23 mm | 23 mm | 23 mm | 23 mm |
© 2019 by the authors. Licensee MDPI, Basel, Switzerland. This article is an open access article distributed under the terms and conditions of the Creative Commons Attribution (CC BY) license (http://creativecommons.org/licenses/by/4.0/).
Share and Cite
Duque, J.S.; Madrigal, B.M.; Riascos, H.; Avila, Y.P. Colloidal Metal Oxide Nanoparticles Prepared by Laser Ablation Technique and Their Antibacterial Test. Colloids Interfaces 2019, 3, 25. https://doi.org/10.3390/colloids3010025
Duque JS, Madrigal BM, Riascos H, Avila YP. Colloidal Metal Oxide Nanoparticles Prepared by Laser Ablation Technique and Their Antibacterial Test. Colloids and Interfaces. 2019; 3(1):25. https://doi.org/10.3390/colloids3010025
Chicago/Turabian StyleDuque, Johan S., Brayan M. Madrigal, Henry Riascos, and Yenny P. Avila. 2019. "Colloidal Metal Oxide Nanoparticles Prepared by Laser Ablation Technique and Their Antibacterial Test" Colloids and Interfaces 3, no. 1: 25. https://doi.org/10.3390/colloids3010025
APA StyleDuque, J. S., Madrigal, B. M., Riascos, H., & Avila, Y. P. (2019). Colloidal Metal Oxide Nanoparticles Prepared by Laser Ablation Technique and Their Antibacterial Test. Colloids and Interfaces, 3(1), 25. https://doi.org/10.3390/colloids3010025

